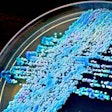
2014 09 08 16 07 08 578 Candida 200

Oral & Maxillofacial Surgery: Page 43
Study: Scientists discover cancer-fighting berry in Australia
October 15, 2014
Review of guidelines can calm Ebola fears
October 15, 2014
AAP 2014: Obese patients more likely to have periodontitis
September 22, 2014
ASTRO: Radiation therapy alone effective for advanced esophageal cancer
September 15, 2014
ASTRO: Blood test could help tailor esophageal cancer treatment
September 14, 2014
Study: Unusual immune cell needed to prevent oral thrush
September 8, 2014
Blood, saliva tests help predict HPV-linked HNC recurrence
August 25, 2014
Study: Coffee may fight periodontal disease
August 21, 2014
Study finds steep decline in edentulism
August 21, 2014
Review weighs new periodontal pathogens
August 21, 2014